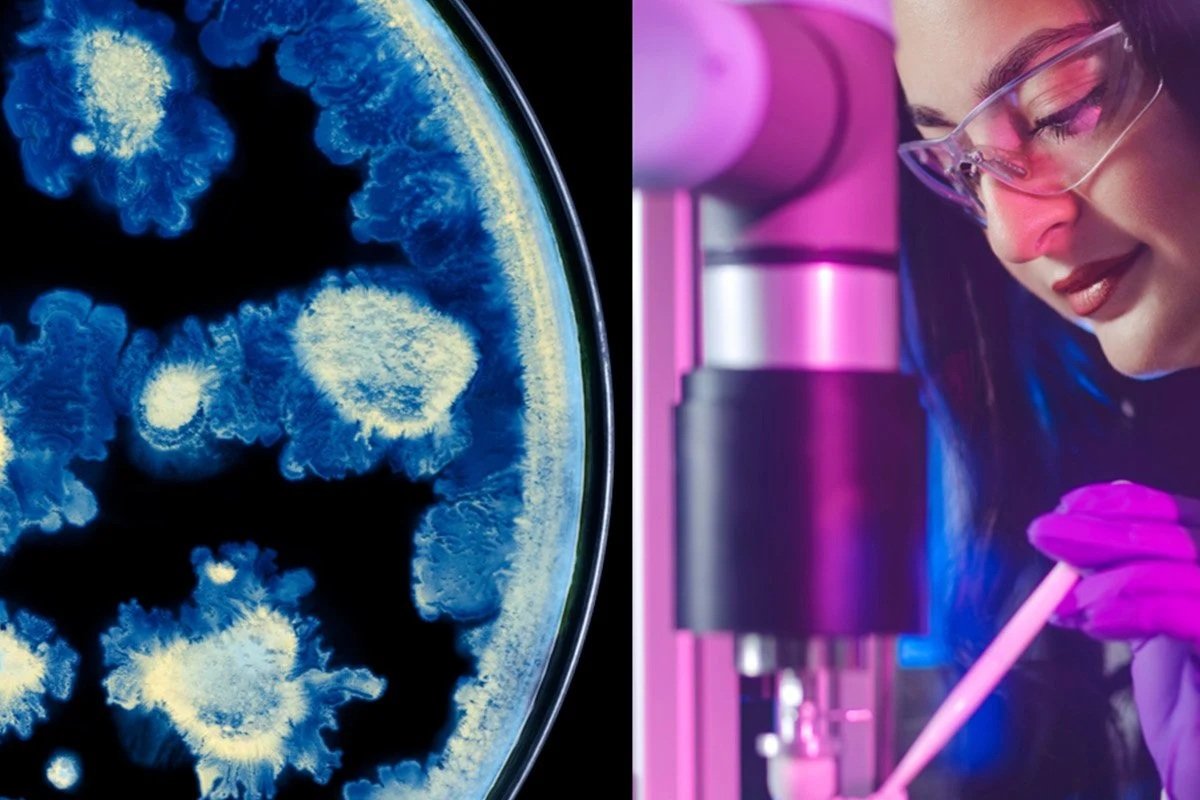
Ricerca L'Oréal e Institut Pasteur: coltura cellulare e scienziata al microscopio per la cura della pelle.

L’Oréal e l’Institut Pasteur hanno annunciato una collaborazione di ricerca definita “storica”, segnando una prima assoluta per entrambe le organizzazioni. Si tratta del primo accordo scientifico di questo tipo tra il celebre centro di ricerca biomedica e uno dei leader globali nelle scienze della pelle.
Questa partnership strategica unisce due istituzioni francesi di primo piano, accomunate dalla convinzione che la pelle sia il testimone silenzioso della salute complessiva, del benessere e della qualità della vita di ogni individuo.
Obiettivi: nuove conoscenze e innovazione
L’alleanza scientifica mira ad approfondire la comprensione della pelle come organo essenziale per la salute umana, accelerando la scoperta di nuovi target biologici e lo sviluppo di ingredienti attivi di nuova generazione per soluzioni avanzate dedicate alla salute cutanea.
Grazie alla sinergia tra l’expertise di L’Oréal nella ricerca avanzata sulla bellezza e quella dell’Institut Pasteur in immunologia, microbioma e biomarcatori cutanei, i team esploreranno il ruolo dei microbi e del sistema immunitario nella salute della pelle attraverso un approccio biologico all’avanguardia.
Leadership nella skin science
“Con questa collaborazione unica con l’Institut Pasteur, stiamo scoprendo la connessione profonda tra la nostra pelle e la salute interna“, ha dichiarato Barbara Lavernos, Deputy CEO responsabile Ricerca, Innovazione e Tecnologia di L’Oréal. “Sottolineando scientificamente l’importanza della salute della pelle, dimostriamo che essa è un organo vitale che riflette la qualità della vita e il suo ruolo fondamentale per la salute di ogni individuo” ha aggiunto Lavernos.
“Collegando l’expertise fondamentale dell’Institut Pasteur in immunologia e scienza del microbioma con l’eccellenza tecnologica di L’Oréal, questo accordo di ricerca mira a decifrare i complessi dialoghi tra cellule cutanee, microbi commensali e difese immunitarie. Insieme, esploreremo come queste interazioni influenzino i processi di invecchiamento accelerato, rivelino condizioni sistemiche di salute e mantengano l’integrità della barriera cutanea” ha sottolineato Yasmine Belkaid, direttrice generale dell’Institut Pasteur.
